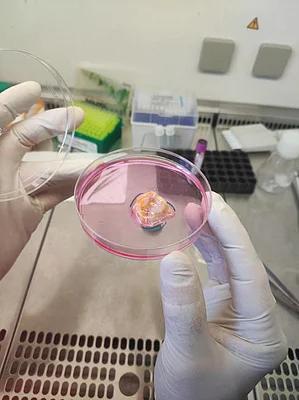

Scroll For More
Score (97)
Abu Dhabi Achieves Cancer Treatment Breakthrough With TIL Therapy Milestone
For the first time in the UAE, researchers have successfully isolated tumour-infiltrating lymphocytes (TILs) from breast and lung cancer tissue — a major milestone that could reshape how cancer is treated in the country. The achievement by the Abu Dhabi Stem Cells Centre (ADSCC) signals the launch of the nation’s first TIL therapy programme, a personalised form of immunotherapy that harnesses a patient’s own immune system to fight cancer. The study, approved as an observational trial by the Department of Health – Abu Dhabi (DoH), marks a leap forward in homegrown medical innovation. Unlike traditional chemotherapy, which can damage both healthy and cancerous cells, TIL therapy focuses the body’s immune response directly on tumours. Doctors extract immune cells from a tumour sample, multiply them in a lab, and reinfuse them into the patient. The result is a potent, patient-specific treatment designed to attack cancer cells from within. “This is a living therapy tailored to the individual,” said Dr Zaima Mazorra Herrera, a lead scientist at ADSCC. She explained that the process effectively transforms the tumour into a personal arsenal of cancer-fighting cells. TIL therapy has already shown success in treating melanoma and is now being explored for other advanced solid tumours, including lung, cervical, and head and neck cancers. ADSCC’s breakthrough brings that potential closer to reality for patients in the UAE. “This capability puts us at the forefront of global medical innovation,” said Prof. Yendry Ventura, Chief Executive Officer of ADSCC. “It also means patients no longer need to travel abroad to access this type of care. We’re building the expertise right here.” Ventura added that the project also strengthens the UAE’s role in global research by contributing valuable clinical data. The programme is being developed in partnership with the Department of Health – Abu Dhabi, Cleveland Clinic Abu Dhabi and SEHA. Together, the organisations are preparing for future clinical trials and the large-scale manufacturing of both TILs and TCR-engineered T cells — another advanced form of cell therapy that modifies a patient’s immune cells to better recognise and attack cancer. Next steps include launching clinical studies to collect tumour samples from eligible patients. Over the next few years, the goal is to make the therapy widely available within the UAE. The announcement comes just ahead of the UAE’s National Day, and Prof. Ventura noted that the breakthrough reflects “the country’s spirit of progress and leadership in healthcare.” TIL therapy remains a highly specialised treatment that’s not yet standard care, but global trials have shown promise, especially for patients with difficult-to-treat tumours. By building capacity now, ADSCC hopes to give UAE patients access to cutting-edge therapies that were once only available abroad. The centre's long-term aim is to integrate TIL and other immunotherapies into a new era of personalised medicine — one where treatment is shaped by each patient’s biology, and not a one-size-fits-all model.

Score (95)
A Self-Driving Taxi Just Became an Unexpected Delivery Room En Route To a San Francisco Hospital
A self-driving taxi in San Francisco just became the most unexpected delivery room in town. On Monday, a woman gave birth inside a Waymo robotaxi while en route to the University of California, San Francisco Medical Center, according to the company. Both mom and baby arrived safely at the hospital — just ahead of emergency responders. The incident marks one of the rare moments when Waymo, the Alphabet-owned self-driving car company, has gone viral for something heartwarming rather than problematic. In recent weeks, Waymo has faced scrutiny over traffic mishaps, including an illegal U-turn in front of police and reports linking its vehicles to the death of a local bodega’s cat. This time, the robotaxi played the role of hero. Waymo said its rider support team detected “unusual activity” inside the vehicle during the trip and quickly reached out to the passenger while simultaneously alerting 911. The company did not explain how the system knew something was wrong, only confirming that help was contacted and that the vehicle completed the trip to UCSF safely. The hospital confirmed the mother and baby were brought in together, but declined to share additional details. “The mother was not available for interviews,” said UCSF spokesperson Jess Berthold. After the impromptu birth, the robotaxi was taken out of service for cleaning. Waymo added that this isn’t the first baby delivered in one of their autonomous vehicles — though it remains a rare occurrence. “We’re proud to be a trusted ride for moments big and small, serving riders from just seconds old to many years young,” the company said in a statement. Waymo’s fleet of driverless vehicles operates throughout San Francisco, Silicon Valley, Los Angeles, and Phoenix, with growing popularity among riders — and increasing scrutiny from critics and city officials alike. Still, for one family in San Francisco, it’s hard to imagine a more memorable ride.

Score (97)
Elusive Blue Arctic Fox Wins 2025 National Wildlife Photo Contest With Fairytale-Like Shot
A blue Arctic fox, a thousand-foot cliff, and a camera hidden behind a tussock. That’s the scene Utah-based photographer Kathleen Borshanian captured on Alaska’s remote St. George Island — and the photo just took top prize in the 2025 National Wildlife Photo Contest. Borshanian’s striking image shows the fox perched near the cliff edge, her kits sleeping nearby, with the wild North Pacific stretching out behind her. The National Wildlife Federation announced her as this year’s grand prize winner, awarding her $5,000 and the top spot out of nearly 30,000 submissions from around the globe. “On the high bluffs of St. George Island, there is a 1,000-foot sea cliff where numerous fox trails cut a path precariously close to the edge,” Borshanian said in a statement. From about 75 feet away, she used a telephoto lens to capture what judges later described as a “fox straight out of a fairy tale.” Now in its 54th year, the annual contest is one of the most respected wildlife photography competitions in the United States. It drew entries from over 3,200 photographers worldwide, each offering glimpses into nature’s beauty and unpredictability. “The stunning images highlight the diversity and majesty of wildlife, plants, and landscapes from across the globe,” said National Wildlife magazine. “In reviewing this year's photo contest entries, our judges noted a couple of unmistakable themes,” wrote Jennifer Wehunt, the magazine’s editorial director. “First, there are astonishing glimpses of nature's sheer strength... And then there are surprises that defy the everyday: a night bus of nautical hitchhikers, a fox straight out of a fairy tale. That ability to amaze—that’s also the power of nature.” Alongside Borshanian’s winning fox, the contest also awarded first and second-place honors in eight categories, including mammals, birds, baby animals, and a special category for young photographers. In the mammals category, Deena Sveinsson won first place with a dramatic shot of three bull moose in Grand Teton National Park, Wyoming. “The photo looks like a movie poster,” Sveinsson said. But getting the shot wasn’t glamorous. She waited for hours and ended up squatting “as low as I could get in the cold, muddy water” to frame it just right. “My socks, pants, and coat got completely soaked with that smelly mud.” In the young nature photographers category, 17-year-old Leo Dale captured a solo coyote in California’s Point Reyes National Seashore during a cloud-streaked sunset. “I’m always on the lookout around dusk,” said Dale, who lives in Sonoma and snapped the photo in fall 2024. Winners came from far beyond North America as well. Ajay Kumar Singh claimed second place in the birds category with a shot of flamingos in Bahrain. The photo was taken at dawn, with city lights still glowing in the background. In the underwater category, Florida’s Remuna Beca earned second place for a striking image of a nurse shark in The Bahamas. “I captured our moment of eye contact,” she said. Photographers interested in next year’s competition won’t have long to wait — entries for the 2026 contest open on January 14. But with this year’s submissions already delivering lava flows in Iceland, fire containment in Pennsylvania, and a Spongebob-shaped fox on an Alaskan cliff, the bar has been set high. As for Borshanian, her award-winning fox may be the star of the show — but the quiet patience and timing behind the lens is what made the magic happen.

Score (97)
Scientists Discover New Species Of Tiny Pumpkin Toadlet In Brazil's Cloud Forests
A tiny, bright-orange frog just over a centimeter long has been officially recognized as a new species in the mountains of southern Brazil — and it now bears the name of the country’s president. Brachycephalus lulai, or B. lulai for short, is the newest member of the pumpkin toadlets, a group of minuscule, vividly colored frogs that live exclusively in Brazil’s Atlantic Forest. Scientists discovered the species deep in the Serra do Quiriri mountain range in the state of Santa Catarina, more than 750 meters above sea level, where the toadlets hide in leaf litter across a sliver of highland forest. Despite their neon hue, the frogs are notoriously hard to find. What ultimately gave this one away was its call. Researchers, who had been cataloguing Brachycephalus species in the region for the past seven years, followed the sound of mating croaks to locate the males. The quieter females were captured more haphazardly. Back in the lab, scientists carried out genetic sequencing and detailed morphological studies to compare the specimens with other pumpkin toadlets. The results were clear: this was a distinct species — and they named it in honor of President Luiz Inácio Lula da Silva. “Through this tribute, we seek to encourage the expansion of conservation initiatives focused on the Atlantic rainforest as a whole, and on Brazil's highly endemic miniaturized frogs in particular,” said herpetologist Marcos Bornschein of São Paulo State University, co-author of the paper published in PLOS One. Though B. lulai lives in a relatively untouched environment and is currently listed as a species of “least concern,” its close relatives in the same region are facing far greater danger. Several of the miniature frogs found nearby are critically endangered, threatened by cattle grazing, grassland burning, deforestation, invasive species, mining, and tourism. Brazil’s Atlantic Forest is one of the most biodiverse ecosystems in the world — and also one of the most fragmented. Amphibians, in particular, are highly sensitive to changes in their environment and are considered the most threatened group of vertebrates globally. To help protect these miniature frogs and their unique habitats, conservationists are pushing for the creation of a federal conservation unit in Santa Catarina. The current proposal would safeguard forest areas without requiring government purchase of private land. Even with this latest discovery, scientists believe many more Brachycephalus species remain undocumented in the mountainous forests of southern Brazil. But there are obstacles. “Further sampling of Brachycephalus species is expected to significantly enhance our understanding of intraspecific variation, while also contributing to the revision of species boundaries,” Bornschein and his colleagues wrote. However, they note that limited funding and the challenge of accessing remote montane areas continue to slow down research efforts — some surveys require opening up kilometers of trails through dense forest. Still, the discovery of B. lulai is a reminder of how much remains hidden in the undergrowth — and how conservation depends on more than just luck. It depends on listening closely, often to the tiniest voices in the forest.

Score (64)
TikTok Star Jordan Howlett Rose to Fame After COVID-19 Halted His MLB Dreams
When Jordan Howlett walked onto the baseball team at UC Riverside, he wasn’t chasing clout. He was chasing the dream — the one where you get drafted, go pro, and make it big. By his senior year, he was in serious conversations with the New York Mets and Arizona Diamondbacks. Then COVID hit, and it was over. “I didn’t want to leave the sport feeling like I could have done more,” Howlett told PEOPLE. “I was very grateful to know I put my absolute everything into baseball.” With pro ball off the table, Howlett was left scrambling for income — and identity. He took fast food jobs, worked 9-to-5 shifts, and tried to make sense of a world that had just flipped on its head. He started filming videos. Just for fun at first. Just to figure out who he was. “Social media wasn’t really a thought for me at that time at all,” he said. He remembered seeing someone with 8,000 followers and thinking, “I’ll never get to that number.” Fast forward to today and @jordanthestallion has over 32 million followers across platforms — a TikTok juggernaut known for his direct-to-camera mirror videos and signature line: “Come here.” Now, he’s up for Storyteller of the Year at the inaugural U.S. TikTok Awards, with the results to be announced December 18. And while the recognition is huge, Howlett admits he almost missed the news entirely. “When you’re in that mode, running around that much, you get tunnel vision,” he said. “I looked up and my manager told me about the nomination. My immediate thought was there’s a laundry list of people on social media that definitely deserve to be there. So I’m just grateful that I’m even considered.” Howlett first found traction with his Fast Foods Secret Club series, sharing insider restaurant tips from his time behind the counter. But what really stuck was him — his energy, honesty, and self-deprecating humor. “People just wanted to watch stuff because of who I was as a person,” he said. “It was very sweet. In sports, you're constantly told you’re a replaceable asset. So to have people who just want to hang out and relate — it’s truly amazing.” That authenticity, plus a background in competition, helped him grow fast. “It turned competitive, in a healthy way,” he said. “I’d see my peers posting consistently, growing, and I wanted to match that work ethic.” Then came the celebrity collaborations. Kevin Hart was the first. “That opened my eyes — like, whoa, we can actually do this with more people,” Howlett said. But working with someone like Hart wasn’t just about clout. It meant real prep, writing, and structure — something very different from Howlett’s usual off-the-cuff style. “I can’t really walk in and be like, ‘We’re just gonna riff,’” he said, laughing. So he wrote jokes. For Kevin Hart. “It was very validating as a writer.” Since then, he’s filmed with stars like Michael B. Jordan and Donald Glover — but the gravity of those moments rarely hits him until later. “It doesn’t hit me until three days later and I’m home like, Oh my gosh, we actually just did that.” Even with all the fame, Howlett’s not gunning for Hollywood. He says he loves traditional media — movies, TV — but doesn’t necessarily want to act. “I’d love to write a little more,” he said. “But what I really want is to create a space where I can help other people from social media show their talents in traditional media fields.” He’s learned that bridging the two worlds isn’t always easy. “Having to explain the importance of social media — especially to people over a certain age — is hard. If you can’t articulate it quickly, they might just blow it off.” But to him, it’s simple: social media is full of real talent. “The rewards are there, and so are the people who are ready for the spotlight.” And those MLB dreams? He doesn’t dwell on what could’ve been. “Of course I would’ve loved it,” he said. “But in the end, [baseball] gifted me with a career I could’ve never imagined. I’m very appreciative of that.”

Score (97)
Gavin Rossdale Attributes Music Success to Early Dog Ownership
Gavin Rossdale has a holiday message he wants everyone to hear loud and clear: adopt, don’t shop. The 60-year-old Bush frontman, longtime animal lover, and proud dog dad is launching a new campaign to help shelter dogs find homes this December. Partnering with Best Friends Animal Society, Rossdale’s “12 Days of Dogmas” campaign will spotlight one adoptable pup each day starting December 10. He’ll feature the dogs on his social media accounts, complete with photos and details on why each one could be your next best friend. “The importance of adopting to me is that you save an innocent life,” Rossdale told PEOPLE. “And the best thing about rescuing a pet is that you think you're doing them the favor, but actually, because life is bizarre and wild, it turns out that they do you the favor.” Rossdale says rescue dogs helped launch his career, got him through some of his toughest days, and continue to bring joy to his life. His first dog, Winston, was a major turning point. “I had to be responsible for him. I couldn't go out for two days straight and be a crazy maniac in London,” he said. “So through my desire to be with him more, I just stayed in more, began to work, had more focus. And that's how I began Bush.” Another dog, Chewy, helped him weather emotional storms. “I rescued him from someone, and he was just incredible. He just gave me so much comfort in the worst times of my life,” Rossdale said. “He was there for me, and I’d just take him everywhere.” While Chewy was small, Rossdale didn’t let that stop him from feeling proud. “It takes a real man to walk a Pomeranian down the road and still feel nice and strong. And I did!” he said. Today, Rossdale shares his life with Kaya, a working dog who keeps him grounded and energized. “I love our 7 a.m. walks, and I love training him. I also love feeding him — lots of canned fish, ancient grains, and good protein, no kibble — to try and keep him healthy.” His three sons, whom he shares with ex-wife Gwen Stefani, are just as smitten. “They've always wanted dogs, so they’re just so over the moon to have a real big dog to play with,” he said. “They missed Chewy so much when he passed, which was two years ago now.” Rossdale has also teamed up with PETA to promote their “Adopt Don’t Shop” campaign, in which he tells the story of Kaya and urges people to stop supporting puppy mills. “Puppy mills are gross,” he said bluntly. “The cliché is that shelter animals are difficult, and that’s just not the case. What they’ve been through is difficult, and what they need is a kind reversal back into life.” His message is simple: when you adopt, everyone wins. “Those animals really need you,” Rossdale said, “and the bond you’ll get and the rewards are immeasurable.”

Score (98)
This Family Opened a Pizza Restaurant To Employ Individuals With Special Needs
A California family’s attempt to help their daughter find work has turned into something much bigger — a pizza shop with a mission, and a message. In the small town of Alpine, just outside San Diego, the Baker family opened Pizzabilities, a restaurant that creates real jobs for people with special needs. The idea came from their 19-year-old daughter, Grace, who has Down syndrome and struggled to find employment. “Finding a job is just very hard with someone with special needs,” said Grace’s father, Josh Baker. So instead of waiting for the right opportunity, the Bakers created one. They had no background in restaurants. But they knew Grace loved two things: pizza and people. That was enough to get started. Last summer, Pizzabilities opened its doors. Grace works there as a proud co-owner, helping to make pizzas from scratch and topping them with her favorite ingredient — pepperoni. But the restaurant has become about more than just pizza. According to Amy Baker, Grace’s mother, the number of job applications from people with special needs has been overwhelming. So many, in fact, that the family believes they could open several more locations based on interest alone. Josh says the most emotional part of the process happens during job interviews. “Tears just start flowing when the kids say, ‘You mean I am really hired?’” he said. “Then you look at their families, and they’re crying because they see their kid get to have an opportunity like the rest of us.” Pizzabilities hasn’t just earned support because of its mission. Customers keep coming back because the food holds up. One customer said he originally stopped in to support the cause but became a regular because of how good the pizza was — from the sauce to the crust. Now the Bakers are thinking bigger. They dream of expanding Pizzabilities into hundreds of locations across the country, and maybe beyond. Printed on the back of every employee’s shirt is a motto that sums it all up: “Where pizzas and abilities rise together.”

Score (95)
Study Suggests Dark Chocolate Could Slow Aging, Thanks To This Key Chemical
Dark chocolate might be doing more than satisfying a sweet tooth — it could be helping to slow down aging. Scientists at King’s College London say they’ve found evidence that theobromine, a naturally occurring compound in cocoa, may have anti-aging effects. Theobromine is the chemical most commonly associated with dark chocolate — and also famously known as being toxic to dogs. The study, published in the journal Aging, analyzed blood samples from 1,669 people and compared their levels of theobromine with biological markers of aging. These markers, which reflect how old a person’s body seems based on health and cellular function rather than actual years lived, are based on changes in DNA methylation and telomere length. Participants with higher concentrations of theobromine in their blood had biological ages lower than their chronological ages, researchers found. “Our study finds links between a key component of dark chocolate and staying younger for longer,” said Professor Jordana Bell, senior author of the study. “While we’re not saying that people should eat more dark chocolate, this research can help us understand how everyday foods may hold clues to healthier, longer lives.” To assess biological aging, researchers used two established tests. One estimated age based on chemical changes to DNA. The other measured the length of telomeres — protective caps at the ends of chromosomes — which tend to shorten as we age. Shorter telomeres are associated with age-related diseases and faster biological aging. The study also explored whether other compounds found in cocoa or coffee had similar effects, but the results pointed specifically to theobromine. “This is a very exciting finding, and the next important questions are what is behind this association and how can we explore the interactions between dietary metabolites and our epigenome further?” said Dr. Ramy Saad, lead researcher on the project. The researchers believe plant-based compounds, like alkaloids, may influence how our genes are expressed over time. Theobromine is one such alkaloid and is already known to have other health benefits, such as improving heart health. But until now, its potential connection to the aging process hadn’t been closely studied. “This study identifies another molecular mechanism through which naturally occurring compounds in cocoa may support health,” said Dr. Ricardo Costeira, a research associate at King’s College London. “While more research is needed, the findings from this study highlight the value of population-level analyses in aging and genetics.” One theory the researchers are now looking into is whether theobromine works alone or in combination with other compounds in chocolate — like polyphenols, which are also known to support human health. That said, the team made it clear this doesn’t mean people should start bingeing on chocolate bars. Dark chocolate, while rich in theobromine, also contains sugar and fat. The researchers emphasized that more work is needed before any health recommendations can be made based on these findings. Still, for those who already enjoy a square of dark chocolate now and then, the news might be a sweet bonus.

Score (96)
Young Raptors Fan Charms Crowd With Adorable Dance Moves During Timeout
The Toronto Raptors may have lost to the New York Knicks on Tuesday night, but a pint-sized fan in the crowd made sure no one left Scotiabank Arena without a smile. During a timeout in the quarterfinal of the NBA In-Season Tournament on Dec. 9, cameras zoomed in on a young Raptors supporter—and that’s when the real show began. Wearing a mini Scottie Barnes No. 4 jersey, the boy lit up the Jumbotron with a full-on dance performance: pumping his fist, bouncing in place, twisting from side to side, and clapping along to the music. At one point, a nearby fan leaned in for a fist bump, and the tiny dancer didn’t miss a beat. The NBA shared the video on social media with the caption, “This young Toronto fan showed off his moves during a timeout,” and the clip quickly went viral. Fans flooded the comments with love for the moment. “He stole the whole game. Adorable,” one person wrote. Another joked, “The Raptors lost, at least he kept us entertained all night.” His mom later showed him the footage on the arena screen, and the kid’s reaction was just as joyful—he clapped his hands, bounced around again, and threw his fist in the air like a seasoned showman. The NBA also posted the video in a joint Instagram post with the Raptors, adding a slow-motion close-up of the boy smiling, waving, and sticking out his tongue. “First he does it with the dance moves, then with the smile and wave 🥹 This @raptors fan is adorable!” the caption read. The Raptors fell to the Knicks 117–110, but if the scoreboard didn’t go their way, at least one little fan walked away a winner.

Score (96)
An American Teen Sold Her Family Painting to Help the British Museum's Redevelopment and Future
A 17-year-old Girl Scout from Virginia is auctioning off a valuable family painting to help save a small museum in the Scottish Highlands. Amelia Cimbalo has spent her summers volunteering at the West Highland Museum in Fort William, a place she now considers her “second home.” For her final Girl Scouts project, she decided to do something bigger than just earning a badge—she started a charity and put a family heirloom up for sale to support the museum’s £6.2 million redevelopment effort. The painting, titled Travellers on a Country Path, Possibly Ayr Beyond, is by the celebrated Scottish artist Alexander Nasmyth. It’s expected to sell for between £3,000 and £5,000 through Lyon & Turnbull, one of the UK’s top fine art auction houses. “I love coming to the Highlands and to the museum, which celebrates the rich history and culture of the West Highlands,” Amelia said. “I really wanted to make a contribution to the Museum’s future and am so excited to see what the painting fetches at auction.” Amelia’s charity, American Friends of Highland Culture, is aimed at supporting cultural institutions across the Highlands. Its stated goal is to “educate and inspire a deeper appreciation for Highlands heritage,” while raising money for local organizations. Her father, Jeff Cimbalo, says he couldn’t be prouder. “I’m so proud of Amelia and of her drive and determination to set up the charity to benefit a whole range of causes, beginning with the West Highland Museum. We’ll both be on tenterhooks on the day of the auction!” The museum, located in Fort William’s Cameron Square, has become a popular stop for Outlander fans, thanks to its extensive Jacobite-era collection. But like many small museums, it’s facing financial pressures. The planned redevelopment will expand gallery space, protect its historic collection, and add new educational facilities for the local community. The painting Amelia is donating isn’t just any landscape. Alexander Nasmyth, born in Edinburgh in 1758, was a pioneer of the Scottish landscape tradition and a close friend of Robert Burns. He’s widely regarded as one of Scotland’s most important early artists. “What an amazing Girl Scout Amelia is, to have established not only a charity for her final Scout project, but one that will support Highland heritage,” said Alice Strang, a senior specialist at Lyon & Turnbull. “Travellers on a Country Path, Possibly Ayr Beyond is a gem of a painting by one of Scotland’s most important artists and its sale will help the West Highland Museum’s exciting redevelopment plans.” For Amelia, it’s a personal cause. While she lives across the Atlantic, her heart—and her charity—are focused on the Highlands.

Score (96)
The Earliest Evidence of Fire-Making was Just Found in England, and Its Rewriting Human History
A team of researchers in the UK says they've found the earliest known evidence that humans knew how to make fire—by choice, not by chance. And it didn’t happen 50,000 years ago, as previously thought. Try more than 400,000. The discovery, published in Nature, pushes back the timeline for fire-making by at least 350,000 years. The site in question is a former Paleolithic settlement in Barnham, England, where ancient humans appear to have mastered one of the most powerful tools for survival: creating fire whenever they needed it. Until now, scientists believed early humans mostly used fire they scavenged from natural sources like lightning strikes or wildfires. But the team behind this study, led by British Museum curator Nick Ashton and project curator Rob Davis, believes the new findings change that picture entirely. So what did they find? Among the soil layers dating back more than 415,000 years, researchers unearthed heat-shattered flint handaxes, a large patch of burned clay that had been repeatedly exposed to extreme temperatures, and two small pieces of iron pyrite. None of these were random. The heated clay—burned to over 700 degrees Celsius (1,292 Fahrenheit)—was found in the same spot as the handaxes and pyrite. That’s not just a campfire. It’s repeated use in the same location, likely a hearth, suggesting early humans knew how to keep the fire going—and maybe even how to start it. Here’s why that matters. Iron pyrite is a mineral that sparks when struck against flint. And it’s not local to Barnham. That means whoever left it there likely carried it in, knowing exactly what it was for. “This rare presence of pyrite in an area where it doesn’t occur naturally suggests intentionality,” the authors wrote. While the team didn’t find physical wear marks on the pyrite or flint to prove they were used to create sparks, the context makes the case compelling. “Fire-making is a uniquely human innovation,” the researchers wrote. “Controlled fire use provided adaptive opportunities that had profound effects on human evolution.” The benefits of fire are obvious—warmth, protection, cooking, light. But the ability to make fire is something else entirely. It freed early humans from having to guard a flame for days or weeks on end. It allowed them to set up camp wherever they liked. And it let them eat cooked food on demand, a critical factor in developing larger brains. The timing is notable. Around 400,000 years ago, humans across Europe were undergoing major changes. Archaeological sites in the UK, France, and Portugal all show signs of intensified fire use from that period. Some experts now believe this is when humans truly started to use fire as a deliberate, daily tool. Before this discovery, the oldest known evidence of fire-making came from Neanderthal sites in France dating to about 50,000 years ago, where handaxes were believed to have been used to strike pyrite and make sparks. The Barnham site predates that by over 350,000 years. Ségolène Vandevelde, an archaeologist at the University of Quebec at Chicoutimi, reviewed the paper and noted that without direct use-wear evidence on the pyrite or handaxes, the claim of intentional fire-making remains just shy of bulletproof. But she agreed the findings were significant. Even with that caveat, the broader implications are hard to ignore. Being able to make fire on demand could have helped humans colonize colder regions, supported social bonding at night, and even helped lead to innovations like adhesive glue for hafted tools. And in a detail unlikely to be missed in Britain: the discovery wrestles the fire-making title away from long-time rivals in France. For a certain kind of archaeologist, that’s likely as satisfying as the science itself. The research adds to growing evidence that fire became a central part of human life much earlier than previously thought—and that the skill of making it wasn’t an accidental discovery, but a deliberate turning point in human evolution.